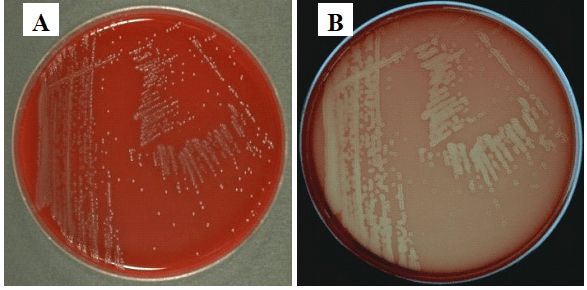

Listeria monocytogenes is a Gram-positive, catalase-positive, non-spore forming, aerobic or anaerobic intracellular rod bacterium in the genus Listeria and family Listeriaceae. L. monocytogenes can also exist as coccobacilli or short chains (resembling Streptococcus and Corynebacteria species) and as saprophytes in the environment. Its motility varies with temperature. L. monocytogenes is motile at 18-20oC with a tumbling motility in liquid media but at 37oC, the bacterium is weakly motile or non-motile.
L. monocytogenes is the main causative agent of listeriosis, a food borne illness (gastroenteritis) in humans especially the immunocompromised, the elderly, transplant patients, infants, pregnant women and those taking immune suppressive drugs. It causes neonatal sepsis and meningitis in neonates and newborns; and it is also implicated in causing sepsis, meningoencephalitis and bacteraemia in the elderly, pregnant mothers and the immunocompromised who are the most people at risk of an infection with L. monocytogenes.
L. monocytogenes is a commonly encountered bacterial pathogen in food products especially vegetables, meat and milk products which they ubiquitously inhabit. The bacterium is a psychrotolerant organism i.e. it can grow at very low temperature such as the refrigerator temperature. Growth at low temperatures allows L. monocytogenes to thrive in refrigerated stored-food products via which likely human infection may occur after consumption. It is noteworthy that low temperatures slow down the growth and multiplication of some pathogenic bacteria and this underlies the reason for preserving food products in the refrigerator.
The main reservoir of L. monocytogenes include animals, fish, vegetables, flies, soil and plants; and it is mainly transmitted through unpasteurized food products (e.g. milk) in human population. It can also be reserved in the intestinal tract of humans (as a member of the intestinal microflora) without causing any significant clinical episode except in immunocompromised persons where morbidity and mortality can occur. L. monocytogenes is ubiquitously found in the environment (especially in agricultural environments) as commensal organisms, and they occasionally cause disease in healthy individuals.
PATHOGENESIS OF LISTERIA MONOCYTOGENES INFECTION
L. monocytogenes is an environmentally ubiquitous bacterium that commonly contaminates food products including those stored in the refrigerator (e.g. cheese, milk, vegetables and meat). The main route via which the pathogen enters the body is via the consumption of food contaminated with L. monocytogenes. After ingestion, the pathogen moves to the gastrointestinal tract where it adheres and is taken up by macrophages and other non-phagocytic cells (through endocytosis).
The attachment and ingestion of L. monocytogenes by phagocytic cells and/or the epithelial cells of the gastrointestinal tract is facilitated by internalins (cell wall surface proteins) produced by the pathogen. Internalins are key virulence factors of L. monocytogenes and they are mainly expressed in two forms viz: InlA and InlB both of which mediate internalization of the pathogen via cellular invasion and tissue tropism (Figure 1).
The two bacterial cell wall surface proteins InlA and InlB interact specifically with adhesion molecules or receptors on the epithelial cells of the host (e.g. E-Cadherin) and this interaction promote the invasion and entry of L. monocytogenes into the host cells including cells of the placenta, intestine and the blood-brain-barrier. L. monocytogenes is an intracellular bacterium, and it produces listeriolysin O (a membrane liquefying and pore-forming enzyme) within the phagolysosome where it is enclosed.
Listeriolysin O (LLO) creates holes on the phagolysosome and promotes rupture, and thus releasing L. monocytogenes into the cytosol of the cytoplasm where further multiplication occurs. Escape of L. monocytogenes from the phagolysosome which is mediated by listeriolysin O prevents damage of the bacterium within the phagosome. This phenomenon allows the bacterium to spread to other nearby cells and even from one epithelial cell to another. L. monocytogenes is able to move rapidly from one cell to another and thus dodge the action of the immune system because it expresses another surface protein known as ActA (Figure 1).
ActA surface proteins facilitates the polymerization of the infected host cell’s cytoplasmic actin filaments, thus forming filaments at the end of L. monocytogenes, and this gives the bacterium a tail of actin which is fastened into the host cell’s cytoskeleton (Figure 2). This phenomenon (i.e. the host cell’s actin filament polymerization) allows L. monocytogenes to move from cell-to-cell within the host without being identified by components of the immune system such as antibodies and complements (Figure 2). Theability of L. monocytogenes to multiply at low temperatures coupled with the virulence factors it produces (e.g. siderophores, listeriolysin O, phospholipase enzyme and internalins) increases the virulence and/or pathogenicity of the bacterium in human hosts.


Complications with L. monocytogenes infection in humans usually occur in pregnant women, and this can lead to stillbirth, premature birth or abortion due to intrauterine infection. L. monocytogenes crosses the placenta and the blood-brain-barrier (BBB), thus causing bacteraemia, sepsis, meningitis and other disseminated infection in neonates or newborns.
L. monocytogenes can also be acquired by newborns from the vagina (birth canal) of an infected mother who has a disseminated infection; and manifestation or clinical episodes of the disease usually occur at a later time in the affected infants. Septicaemia, endocarditis and impairment of the CNS can also occur in the immunocompromised host and even in transplant patients. There is a low carriage of the bacterium in healthy adults and children where an asymptomatic diarrheal infection, abdominal cramp, and fever usually occur.
LABORATORY DIAGNOSIS OF LISTERIA MONOCYTOGENES INFECTION
The laboratory diagnosis of L. monocytogenes requires the identification of the pathogen by culture and microscopy. Blood, cerebrospinal fluid (CSF) and focal lesions are the primary specimens obtained from infected patients for analysis. Mueller-Hinton agar and blood agar (BA) are preferably used for the cultivation of L. monocytogenes in the laboratory. L monocytogenes produces small, grayish, haemolytic and translucent colonies on BA (Figure 3).
Culture plates are incubated for 48 h at temperature range of 3-40oC. Selective media (e.g. Listeria oxford agar base) also exist for the isolation of L. monocytogenes from clinical and environmental samples. L. monocytogenes also grow on Oxoid Brilliance Listeria agar (OBLA) plate causing haemolysis (Figure 4). L. monocytogenes forms beta-haemolysis on blood agar, and its rods resemble corynebacteria. The isolation of L. monocytogenes is enhanced if the specimen is kept for some number of days in the refrigerator (at 4oC) before culturing.
L. monocytogenes is Gram-positive, catalase positive, and motile; and its colonies forms beta-haemolysis on blood agar. The pathogen ferments carbohydrates (e.g. glucose and maltose) to produce acid but not gas. Polymerase chain reaction (PCR) and ribotyping are the two molecular techniques employed in the detection of the parasite; and the molecular subtypes of the organism can be detected by pulse-field gel electrophoresis (PFGE).

IMMUNITY TO LISTERIA MONOCYTOGENES INFECTION
L. monocytogenes is an intracellular bacterial pathogen, thus immunity to infections caused by the organism is cell-mediated. The ability of the pathogen to multiply inside the cell gives it ability to evade attack by antibodies, complements and other components of the host’s immune system. L. monocytogenes produces and utilizes eukaryotic actin, a protein-like molecule that allows the pathogen to evade immune system attack, and thus enable it to move rapidly and freely through the epithelial cells without being detected by the host’s immune system mechanisms.
Nevertheless, the T-helper cells (CD4+) and T-cytotoxic cells (CD8+) are strongly involved in mounting an effective response against L. monocytogenes invasion of the human body cells. People most susceptible to infection by L. monocytogenes include newborns, immunocompromised patients, pregnant women and the elderly.
TREATMENT OF LISTERIA MONOCYTOGENES INFECTION
Sulphamethoxazole-trimethoprim, penicillin G, erythromycin, fluoroquinolones, vancomycin and ampicillin are the drugs of choice for the treatment of listeriosis. Early treatment of infected individuals (including the elderly, pregnant women and the immunocompromised) with any of these agents or a combination of them (according to the guidelines of a physician) is effective in aborting complications due to L. monocytogenes infection. No vaccine currently exists for listeriosis.
PREVENTION AND CONTROL OF LISTERIA MONOCYTOGENES INFECTION
Incidence of L. monocytogenes infections amongst humans could be reduced by taking precautions when consuming some foods. Some type of food meant for human consumption (e.g. salads, sandwiches, vegetables, pork meat, cheeses, milk, and other dairy and fermented food products) can become infected by L. monocytogenes at anytime during food processing and food cultivation. L. monocytogenes is a psychrotolerant bacterial pathogen, and thus refrigeration (i.e. cold temperature) which normally inhibits the growth of most bacterial pathogens is ineffective in limiting its growth.
Rather, refrigeration enhances the growth of the pathogen especially when it is already present in the stored food. L. monocytogenes is an important food-borne pathogen that is of public health interest due to its ubiquity and ease of contaminating food meant for human consumption. Thus, proper care should be taken in the handling and processing of food in order to reduce the rate of contamination. L. monocytogenes is a widely distributed bacterial pathogen, and thus the risk of contamination is high.
As a way of prevention and control of the disease, immunocompromised individuals, the elderly and pregnant mothers should be cautious and avoid unpasteurized dairy and ready-to-eat meats and foods as much as possible since these food sources are the main route via which the pathogen gets transmitted to humans. Food processing companies and food vendors should endeavour to always abide and observe the hygienic principles associated with their businesses so that the rate of transmission of L. monocytogenes could be reduced.
OTHER SPECIES OF LISTERIA
- L. ivanovii:Listeria ivanovii is the second pathogenic species in the genus Listeria after L. monocytogenes (that causes listeriosis after the consumption of food contaminated by the organism). The organism rarely occurs in humans, but L. ivanovii is an enteric opportunistic human pathogen that can cause zoonotic infections in humans. L. ivanovii is mainly found in ruminants; and it causes septicaemia that usually leads to enteritis, neonatal sepsis and abortion in ruminants.
- L. innocua: L. innocua is a non-pathogenic Listeria species that is ubiquitously found in the environment including the soil, water, vegetation, wild and domesticated animals, and humans and even in food sources. The organism can survive in extreme environmental conditions such as high salt concentration, low and high temperatures and in acidic and alkaline environments. L. innocua is a harmless species of the genus Listeria that is not known to cause listeriosis or any related infection in humans or animals.
- L. welshimeri: L. welshimeri is a non-pathogenic species of the genus Listeria. Like L. innocua, this organism is harmless, and it has not been reported to cause infection in humans or animals. It is found in the environment especially on vegetations. L. welshimeri is non-haemolytic, non-spore forming, motile and facultatively anaerobic in nature.
- L. seeligeri: L. seeligeri is a haemolytic species of Listeria. L. monocytogenes and L. ivanovii are the other haemolytic species of Listeria. It is non-pathogenic in nature. L. seeligeri is widely found in the environment especially in plants, soil, and animal feces.
- L. grayi: L. grayi is a non-pathogenic Listeria species like L. innocua. It is non-haemolytic in nature, non-spore forming, motile and facultatively anaerobic in terms of its physiological features.
References
Brooks G.F., Butel J.S and Morse S.A (2004). Medical Microbiology, 23rd edition. McGraw Hill Publishers. USA. Pp. 248-260.
Madigan M.T., Martinko J.M., Dunlap P.V and Clark D.P (2009). Brock Biology of microorganisms. 12th edition. Pearson Benjamin Cummings Publishers. USA. Pp.795-796.
Prescott L.M., Harley J.P and Klein D.A (2005). Microbiology. 6th ed. McGraw Hill Publishers, USA. Pp. 296-299.
Ryan K, Ray C.G, Ahmed N, Drew W.L and Plorde J (2010). Sherris Medical Microbiology. Fifth edition. McGraw-Hill Publishers, USA.
Singleton P and Sainsbury D (1995). Dictionary of microbiology and molecular biology, 3rd ed. New York: John Wiley and Sons.
Talaro, Kathleen P (2005). Foundations in Microbiology. 5th edition. McGraw-Hill Companies Inc., New York, USA.
Discover more from Microbiology Class
Subscribe to get the latest posts sent to your email.
